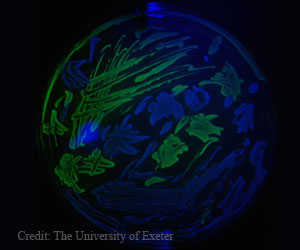
Antibiotics Stimulate the Growth of Bacteria

A new molecular pathway has been discovered by researchers that control the production of Shiga toxins in deadly Enterohemorrhagic E. coli (EHEC) infections.

TOP INSIGHT
Researchers have discovered a very short piece of Shiga toxin messenger RNA which is made into a regulatory non-coding RNA which silences the toxin and promotes the growth of Enterohemorrhagic E. coli (EHEC). This pathway has the potential to be a drug target in the treatment of EHEC infections.
Read More..
Currently, there is no treatment for EHEC infections. Antibiotics are generally not recommended as they stimulate the production of Shiga toxin.
The researchers identified a new target which can be used for drug development that can suppress Shiga toxin during EHEC infection.
Contracting Enterohemorrhagic E. coli (EHEC) Infection
There are several ways in which people can be infected with EHEC.
- They come into direct contact with the feces of cows and sheep as EHEC can be found in their feces
- They are directly or indirectly through surfaces in contact with tiny feces from an infected person
- They ingest EHEC strain by eating undercooked minced meat, contaminated fresh produce like vegetables or drinking contaminated water or unpasteurized milk.
The prevalence of EHEC is low compared to other foodborne pathogens. However, the disease could be very severe or even fatal. The most significant outbreak of EHEC was in South Australia in 1995. It was caused due to contaminated mettwurst. Mettwrust is a semi-dry fermented sausage which is made from the raw minced port which is preserved by curing and smoking.
This episode of EHEC triggered a major food safety investigation and outbreaks since 1995 have been smaller.
Shiga toxin-producing E. coli is still a major food safety concern after a large outbreak occurred in Germany in 2011. The strain was spread mostly through contaminated sprouts or close contact with an infected person.
New pathway 'hiding in plain sight'
The discovery of the new pathway by the researchers is the first discovery in 20 years.
An earlier study in 2001 found that the production of Shiga toxin was controlled by a bacterial virus, known as a bacteriophage, within the genome.
In the current study, the researchers found a very short piece of Shiga toxin messenger RNA which is made into a regulatory non-coding RNA which silences the toxin and promotes the growth of the pathogen.
The recent advances in RNA sequencing technology were used to detect the presence of the new regulatory non-coding RNA embedded within the Shiga toxin messenger RNA.
For almost 20 years this new regulatory non-coding RNA had been hiding in plain sight because around 7000 studies have focused on Shiga toxin.
Implications for Treating EHEC Infections
The finding of the novel pathway opens up new possibilities for the treatment of EHEC infections
"Our work shows a new mechanism for controlling toxin production that may be amenable to new RNA-based therapeutics to inhibit toxin production during infection. We anticipate this would expand intervention options and potentially allow the use of antibiotics that are currently not recommended because they stimulate Shiga toxin production,” Dr. Tree said.
The researchers are looking forward to testing these new interventions in the next stage of their research.
Source-Medindia
MEDINDIA

Email






